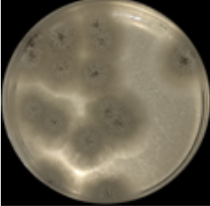

JimmyHo
Hello
My name is Ho Chun Lung
Hi, I'm an engineering student with a passion for applying technology to real-world problems. I've worked on a diverse range of projects including a gas analyzer, UI design, web crawler, disinfection system and chatbot development. I enjoy exploring different aspects of hardware and software development and finding creative solutions to complex problems.

Beagle
Beagle is a non-invasive gas analyzer designed to separate and differentiate compounds in the gas mixture. Aimed to detect specific volatile organic compounds (VOCs) for metabolic biomarkers, Beagle secures your health status in a huff of breath.
This project is done during an internship at King's Phase Technologies. And I am responsible for the project algorithm and UI design

UI Design




Web Crawler
The web crawler project, in collaboration with CUHK and InvestHK, collects and analyzes financial news from Hong Kong and China. Using advanced web scrapings techniques such as selenium and web driver, we provide investors and analysts with up-to-date insights to inform investment decisions and stay ahead of the curve.




Chatbot Development
Our chatbot development project uses cutting-edge technologies to provide users with fast and accurate responses to their queries. By tokenizing our own datasets and leveraging the power of llama_index and GPT, we are able to analyze large amounts of data and generate responses in real-time.
In the project, the chatbot can tokenize experimental data and answer the querying. Also, the chatbot can predict the answer after giving the prediction rules.
Disinfection System
FYP project done in CUHK.
During the outbreak of Covid-19, this project aims to develop a localized air disinfection system for the public which will instead be the air purifier for restaurants and schools.
This project is mainly focusing on building a cost-effective and localized design for the air disinfection system. Compared with air purifiers, the cost of the device is 1/10 of the air purifier.
To ensure the efficiency of the localized purifier, it is tested with Aerosolized E. coli.
After the experiment, the disinfection rate is nearly 90%.